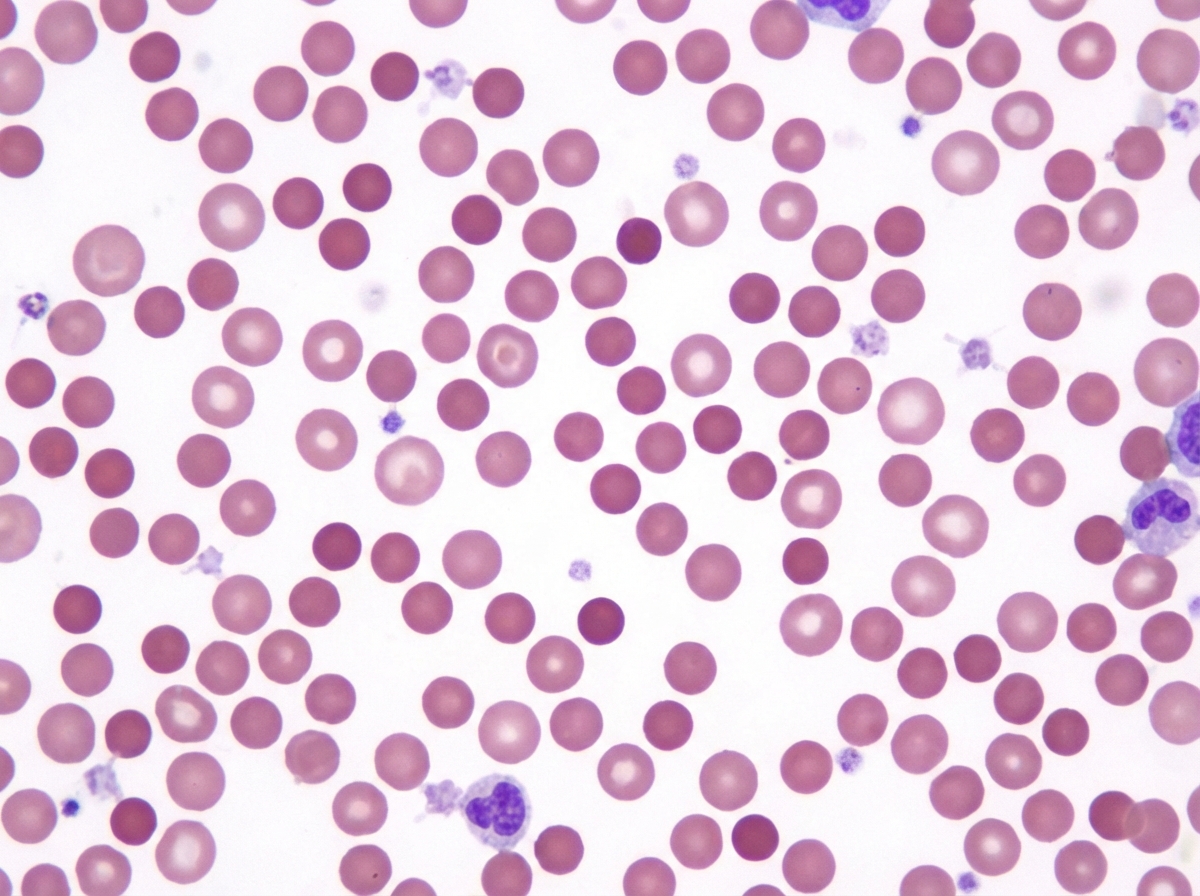
Image for question 57

Enter your email to get your 85% OFF code and unlock the full USMLE question bank on the app.
A 36-year-old man presents to his primary care physician with increasing fatigue. He says that the fatigue started after he returned from vacation in South America 4 weeks ago and thinks that it may be related to an infection he got while abroad. He does not know the name of the infection but says that he went to a local clinic for treatment and was given an antibiotic. Since then, he has noticed that he is no longer able to perform his job as a contractor who renovates old homes because he feels short of breath after just a few minutes of work. Furthermore, he says that he has been experiencing prolonged nosebleeds that never occurred prior to this episode. He denies any neurologic symptoms. His past medical history is significant for alcoholic hepatitis secondary to alcohol abuse 3 years prior. Physical exam reveals conjunctival pallor as well as petechiae. Which of the following findings is associated with the most likely cause of this patient's symptoms?
A 16-year-old male presents to the emergency department with a hematoma after falling during gym class. He claims that he has a history of prolonged nosebleeds and bruising/bleeding after minor injuries. Physical exam is unrevealing other than the hematoma. Labs are obtained showing an increased bleeding time and an abnormal ristocetin cofactor assay. Coagulation assays reveal an increased partial thromboplastin time (PTT) but a normal prothrombin time (PT). The patient is given desmopressin and is asked to avoid aspirin. Which of the following findings is most likely directly involved in the etiology of this patient's presentation?
A 66-year-old man is admitted to the medical floor after being diagnosed with community-acquired pneumonia. He has been in good health except for the use of steroids for the past 6 months for ulcerative colitis. The patient is started on the empiric therapy with ceftriaxone for the management of pneumonia. After 10 days of treatment in the hospital, he becomes tachypneic with a decreased level of consciousness. He develops generalized pustular eruptions all over his trunk. The temperature is 40.8°C (105.4°F), and the white blood cell count is 19,000/mm3. The gram stain of an aspirate shows many budding yeasts and neutrophils. A culture of the skin specimen is positive for Candida albicans. The nitroblue tetrazolium test is normal. What is the most likely condition related to his signs and symptoms?
A 24-year-old healthy male presents to the emergency room complaining of severe abdominal pain. He reports that he was playing rugby for his college team when he was tackled on his left side by a member of the opposing team. He is currently experiencing severe left upper abdominal pain and left shoulder pain. A review of his medical record reveals that he was seen by his primary care physician two weeks ago for mononucleosis. His temperature is 99°F (37.2°C), blood pressure is 90/50 mmHg, pulse is 130/min, and respirations are 26/min. He becomes increasingly lethargic over the course of the examination. He demonstrates exquisite tenderness to palpation over the left 8th, 9th, and 10th ribs as well as rebound tenderness in the abdomen. He is eventually stabilized and undergoes definitive operative management. After this patient recovers, which of the following is most likely to be found on a peripheral blood smear in this patient?
A 25-year-old man comes to the physician for the evaluation of recurrent episodes of nosebleeds over the past 6 months. The nosebleeds occur spontaneously and stop after 10 minutes after pinching the nose at the nostrils. He has no history of serious illness except for prolonged bleeding following wisdom teeth extraction 2 years ago. He does not smoke or drink alcohol. He takes no medications. Vital signs are within normal limits. Examination of the nose shows no abnormalities. There are several bruises on the lower extremities. The remainder of the examination shows no abnormalities. Laboratory studies show: Hemoglobin 15 g/dL Leukocyte count 6,000/mm3 Platelet count 220,000/mm3 Bleeding time 9 minutes Prothrombin time 13 sec Partial thromboplastin time 55 sec Which of the following is the most likely diagnosis?
A mother brings her 6-year-old daughter in to the pediatrician’s clinic for a wellness visit. The mother has a history of von Willebrand’s disease (vWD) and is concerned that her daughter may be affected as well. The mother tells you that she has noticed that her daughter bruises very easily, and her bruises typically are visible for a longer period of time than those of her brother. She denies any personal history of blood clots in her past, but she says that her mother has had to be treated for pulmonary embolism in the recent past. Her birth history is significant for preeclampsia, preterm birth at 32 weeks, a NICU stay of two and a half weeks, and retinopathy of prematurity. She currently eats a diet full of green vegetables, fruits, and french fries. Her vital signs include: temperature, 36.7°C (98.0°F); blood pressure, 106/54 mm Hg; heart rate, 111/min; and respiratory, rate 23/min. On physical examination, her pulses are bounding, complexion is pale, scattered bruises throughout all extremities that are specifically scattered around the knees and elbows. After ordering a coagulation panel, which of the following would one expect to see in the lab panel of a patient with vWD?
A 27-year-old woman presented to the clinic with recurrent abdominal swelling and stunted growth relative to her siblings. She has a history of multiple blood transfusions in her childhood. She has a family history of jaundice in her father who was operated on for multiple gallbladder stones. The physical examination reveals a pale, icteric, small and short-statured young lady. On abdominal examination, the spleen was enlarged by 6 cm below the right costal margin, but the liver was not palpable. The ultrasound of the abdomen reveals multiple gallbladder stones. The laboratory test results are as follows: Hb 9 g/dL Hct 27% WBC 6,200/mm3 Platelets 200,000/mm3 MCV 75 um3 MCHC 37 gm/dL Reticulocytes 6.5% A peripheral blood smear is presented in the image. The direct Coombs test was negative. The osmotic fragility test was increased. What is the most likely cause of her condition?
A 9-year-old boy is brought to the physician by his mother because of a 3-day history of fever and bleeding after brushing his teeth. His mother also reports that her son has asked to be picked up early from soccer practice the past few days because of fatigue. He appears pale and ill. His temperature is 38.3°C (101.1°F), pulse is 115/min, and blood pressure is 100/60 mm Hg. The lungs are clear to auscultation. Examination shows a soft, nontender abdomen with no organomegaly. There are several spots of subcutaneous bleeding on the abdomen and shins. Laboratory studies show a hemoglobin concentration of 7 g/dL, a leukocyte count of 2,000/mm3, a platelet count of 40,000/mm3, and a reticulocyte count of 0.2%. Serum electrolyte concentrations are within normal limits. A bone marrow biopsy is most likely to show which of the following findings?
A 46-year-old woman presents to your office with oral lesions as shown in Image A. On examination, you find that her back has flaccid bullae that spread when you apply lateral pressure with your fingertips. This patient most likely has autoantibodies directed against which of the following?

A 12-year-old boy is found on a routine auditory screening to have mild high frequency hearing impairment. On exam, he has no ear pain, no focal neurological deficits, and no cardiac murmurs. He has not had any recent illness. Laboratory studies show: Serum: Creatinine: 0.7 mg/dl Protein: 3.8 g/dl Antistreptolysin O titer: 60 Todd units (12-166 normal range) Urinalysis: Microscopic heme Protein: 4+ RBCs: 6/hpf A kidney biopsy is taken. Which of the following findings is most characteristic of this patient’s disease?
Liver pathology (hepatitis, cirrhosis)
Practice Questions
Gallbladder and biliary tract disorders
Practice Questions
Pancreatic diseases
Practice Questions
Kidney diseases
Practice Questions
Male reproductive pathology
Practice Questions
Female reproductive pathology
Practice Questions
Breast pathology
Practice Questions
Endocrine pathology
Practice Questions
Bone and joint pathology
Practice Questions
Skeletal muscle diseases
Practice Questions
Peripheral nerve disorders
Practice Questions
Soft tissue tumors
Practice Questions
Head and neck pathology
Practice Questions
Get full access to all questions, explanations, and performance tracking.
Scan to download app